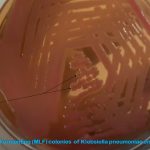
MacConkey Agar: Introduction, Principle, Composition, Preparation, Procedure, Colony Morphology and Uses

Tag: Further Readings on MacConkey Agar
MacConkey Agar: Introduction, Principle, Composition, Preparation, Procedure, Colony Morphology, Uses and Keynotes
 Introduction of MacConkey Agar MacConkey agar(MAC) uses for the culture...
Introduction of MacConkey Agar MacConkey agar(MAC) uses for the culture...
Introduction of MacConkey Agar MacConkey agar(MAC) uses for the culture...
Introduction of MacConkey Agar MacConkey agar(MAC) uses for the culture...